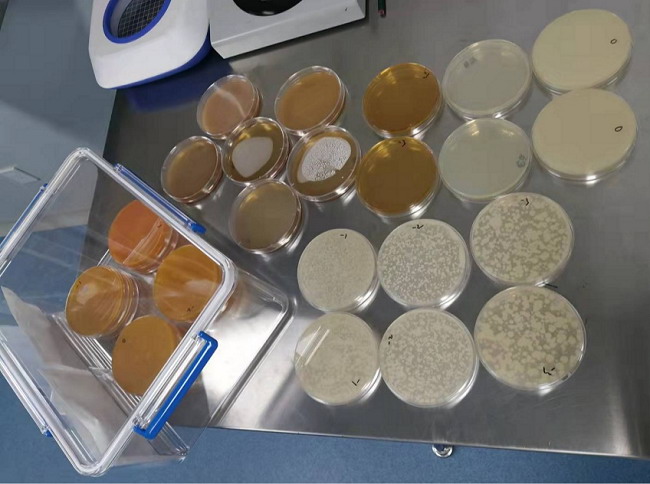

发挥技术优势 解决企业难题 甘肃省食品检验研究院获企业赞许
自开展“我为群众办实事”实践活动以来,甘肃省食品检验研究院立足职能职责,发挥技术支撑作用,把满足企业技术需求,作为衡量为群众办实事成效的标准之一。近日,兰州三叶食品有限公司再次来我院探讨技术难题,同时将一面印有“心系企业助发展 高效服务解难题”的锦旗赠至我院,对我院专业技术人员为公司质量提升提供的技术帮扶,帮助其及时摆脱技术困扰的行为表示感谢。

为全面落实省局“防疫情、保稳定、促发展”总体安排部署,省食检院深入企业一线开展“一对一、手把手”进行技术指导活动,有效解决企业遇到的食品检验检测技术难题。2022年新年伊始,兰州石化集团下属三叶食品有限公司新型生产设备投入使用,在新产品开发环节中被食品灭菌问题困扰,如果片面保持食品自然风味会导致卫生指标不合格,高温杀菌又会影响食品营养与口感,如何找到一个最佳的技术点成为一道难题,从而将影响到研发及后续生产活动。


为真正解决企业难题,省食检院得知此情况后,及时安排产业发展服务室专业技术人员主动与企业进行沟通,在全面了解企业存在的问题后,我院专业技术人员毫不推辞,结合企业实际,及时成立技术公关小组,针对此问题设计了多重食品灭菌方案,通过灭菌效果与口感分析,确定了最佳技术参数,最大限度地把产品的优势展现出来。不仅授人以鱼,省食检院还授人以渔,同时传授技术到企业一线,对数据处理等关键环节向企业检验人员进行了认真细致的讲解,使企业检验人员熟练掌握了新方法,为今后工作顺利开展奠定了坚实的基础。此次技术帮扶活动以企业实际需求为出发点,提供有针对性、差异性服务,实打实地帮助企业解决灭菌并提升口感的实际问题和技术难题,进一步加强了企业对食品质量把控能力。

自党史学习教育“我为党旗添光彩、为群众办实事”主题实践活动开展以来,省食检院紧紧围绕“实”字做文章,充分发挥技术优势,将检验与服务有机结合,组织专业技术人员组成食品科技志愿服务队,深入食品企业一线开展送培训、送技术活动,将企业一线作为专业技术人员的实践课堂,向企业检验人员讲解食品检验新技术、解疑释惑,有效解决了食品企业加工生产过程中遇到的各类问题,帮助企业解决技术难题,促进食品企业健康发展。至目前,全院深入食品企业开展各类专业技术指导200多场次,受益企业一线检验人员1000人次以上。
志愿服务,技术先行。下一步,省食检院将以志愿服务活动为契机,把服务企业作为自身发展动力,坚持把产学研结合作为融入经济建设的切入点,充分发挥专业技术优势,常态化开展“我为党旗添光彩、为群众办实事”食品检验志愿服务行动,引导全体职工积极投身文明单位创建,关爱他人、回报社会、提升自我,传递食检正能量,为全省食品经济发展增砖添瓦。